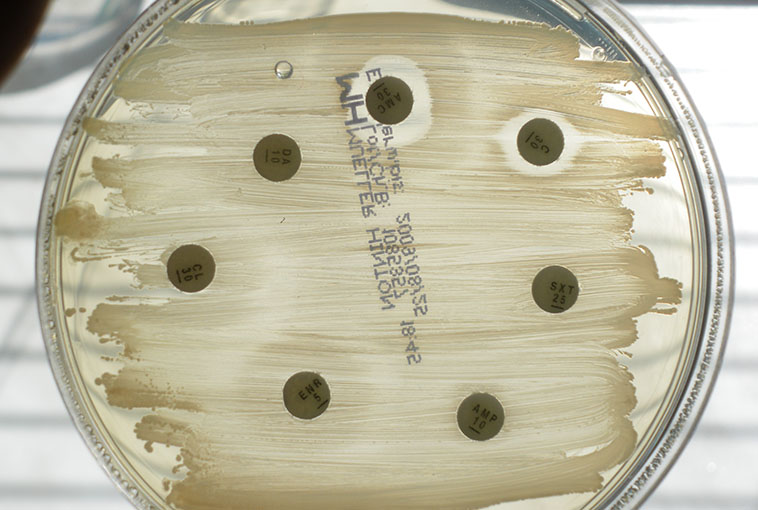

29 жовтня, 2019
Энтерококковая бактериемия у детей и подростков с нейтропенией при наличии злокачественных новообразований и клиническое влияние устойчивости к ванкомицину на исход основного заболевания
Энтерококки являются частой причиной бактериемии у пациентов с ослабленным иммунитетом. Хотя увеличение количества ванкомицинрезистентных энтерококков (ВРЭ) затрудняет соответствующую антибактериальную терапию, клинические признаки энтерококковой бактериемии (ЭКБ) и влияние инфекции ВРЭ на исход заболевания редко встречаются у детей с ослабленным иммунитетом.
Методы. В исследование были включены дети и подростки (в возрасте до 19 лет) со злокачественными новообразованиями, у которых была диагностирована ЭКБ при нейтропении c 2010 по 2017 год. Медицинские записи зарегистрированных детей были подвергнуты ретроспективной оценке с точки зрения клинических характеристик ЭКБ и ее влияния на исход заболевания.
Результаты. 36 эпизодов ЭКБ были выявлены у 30 пациентов. Инфекцию ВРЭ обнаружили в 11 случаях (30,6%); 7- и 30-дневная смертность составила 27,8 и 44,4% соответственно. При этом наиболее распространенными основными заболеваниями были острый лимфобластный лейкоз (50,0%) и острый миелобластный лейкоз (30,6%). Три (8,3%) пациента находились в стадии полной ремиссии, паллиативная и реиндукционная химиотерапия проводились в 47,2 и 36,1% случаев соответственно. Эмпирическая антибактериальная терапия была уместна у 64,0% больных с ванкомицинчувствительной энтерококковой инфекцией и ни у одного из ВРЭ‑инфицированных пациентов (р=0,001). Тем не менее уровень 30-дневной смертности существенно не отличался между двумя группами пациентов (44,0 против 45,5%).
Выводы. Большинство случаев ЭКБ наблюдалось на поздних стадиях основных злокачественных новообразований и приводило к высокой смертности. Прогноз, по-видимому, связан с основным заболеванием, а не ВРЭ, хотя число зарегистрированных пациентов было небольшим.
Bae K. S. et al. Enterococcal bacteremia in febrile neutropenic children and adolescents with underlying malignancies, and clinical impact of vancomycin resistance. Infection. 2018 Dec 19.
Медична газета «Здоров’я України 21 сторіччя» № 19 (464), жовтень 2019 р.